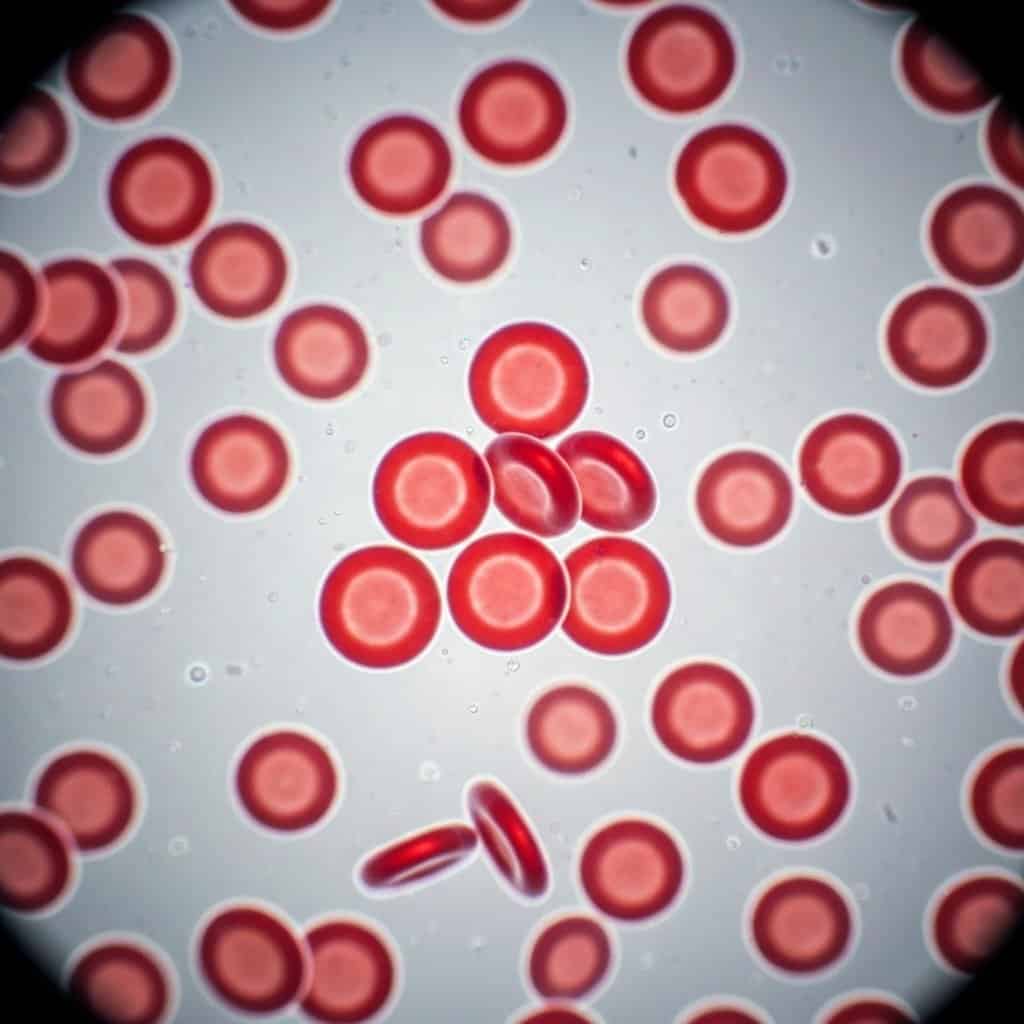
Hematokryt – co to jest i dlaczego jest ważny?

Na Topie
Biznes i finanse
Kryminalizacja pomocy humanitarnej w Europie: Zagrożenie dla wartości i praw człowieka
Wprowadzenie do problemu
W ostatnich latach obserwujemy niepokojący trend w wielu krajach europejskich – kryminalizację pomocy humanitarnej. To zjawisko, które polega na wprowadzaniu przepisów prawnych...
Praktyczne zastosowania sztucznej inteligencji w medycynie
Sztuczna inteligencja (AI) rewolucjonizuje wiele dziedzin życia, a medycyna jest jedną z tych, gdzie jej potencjał jest szczególnie widoczny. Od diagnostyki po personalizowane terapie,...
Zdrowie i uroda
Neural Engine: Rewolucja w przetwarzaniu danych w urządzeniach
Czym jest Neural Engine i jak działa?
Neural Engine to specjalizowany procesor, zaprojektowany do wydajnego wykonywania zadań związanych ze sztuczną inteligencją i uczeniem maszynowym. W...
NAJNOWSZE ARTYKUŁY
Bezpieczeństwo płatności mobilnych: Twój przewodnik po cyfrowych transakcjach
Płatności mobilne stały się nieodłącznym elementem naszego codziennego życia. Szybkie, wygodne i coraz powszechniejsze, pozwalają nam na płacenie za zakupy, bilety czy usługi za...
Jak media przedstawiają obraz imigranta w Polsce?
Obraz imigranta w polskich mediach jest złożony i często kształtowany przez różne czynniki, od polityki po bieżące wydarzenia społeczne. Analiza sposobu, w jaki media...
Amortyzacja w firmie: co i jak można amortyzować?
Czym jest amortyzacja i dlaczego jest kluczowa w biznesie?
Amortyzacja to proces stopniowego obniżania wartości środków trwałych i wartości niematerialnych i prawnych w firmie, odzwierciedlający...
Ile kosztuje projekt kuchni u architekta wnętrz?
Czym jest projekt kuchni i dlaczego warto zainwestować w profesjonalistę?
Projekt kuchni to znacznie więcej niż tylko wybór mebli i kolorów. To kompleksowe podejście do...
Czy steamer może zastąpić żelazko? Rozwiewamy wątpliwości.
Wstępne porównanie: Steamer a tradycyjne żelazko
W świecie mody i dbania o wygląd, utrzymanie ubrań w idealnym stanie jest kluczowe. Przez lata żelazko było podstawowym...
Ceramika ochronna: Kompleksowa ochrona lakieru Twojego samochodu
Ceramika ochronna to innowacyjne rozwiązanie, które zdobywa coraz większą popularność wśród właścicieli samochodów dbających o nienaganny wygląd i długowieczność lakieru. Jest to zaawansowana forma...
ABAC: Rewolucja w Kontroli Dostępu w Erze Cyfrowej
W dzisiejszym świecie, gdzie dane są nową walutą, a bezpieczeństwo informacji stanowi priorytet, tradycyjne metody zarządzania dostępem do zasobów cyfrowych okazują się niewystarczające. Coraz...
Hematokryt – co to jest i dlaczego jest ważny?
Czym jest hematokryt? Definicja i podstawowe informacje
Hematokryt to jeden z kluczowych parametrów określających skład krwi, który informuje nas o proporcji objętości erytrocytów, czyli czerwonych...
Kolejki do lekarzy specjalistów: Dlaczego problem narasta i co można z tym zrobić?
Długie oczekiwanie na wizytę – powszechny problem pacjentów
Kolejki do lekarzy specjalistów to realny problem polskiego systemu ochrony zdrowia, dotykający setki tysięcy pacjentów rocznie. Zamiast...
Analiza logów serwera dla zaawansowanego technicznego seo
Analiza logów serwera to kluczowy element zaawansowanego technicznego seo, który pozwala na głębokie zrozumienie interakcji między botami wyszukiwarek a stroną internetową. Zbieranie i interpretowanie...